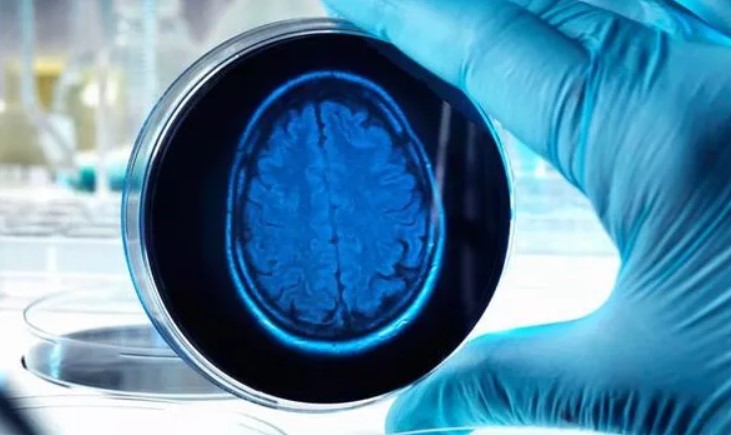
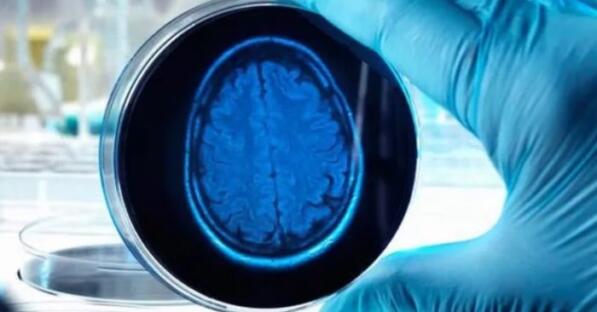

Nghiên cứu chấn động: Những bộ óc nhân tạo cũng biết suy nghĩ!
Gần đây, các nhà khoa học thành công trong việc nuôi một phần não người trong phòng thí nghiệm để nghiên cứu. Sẽ thế nào nếu bộ não nhân tạo biết suy nghĩ và có cảm giác? Nếu chuyện đó xảy ra thì việc nuôi cấy não người này sẽ đi quá ranh giới về đạo đức.
Có rất nhiều nơi đã làm về thí nghiệm loại này, nhưng trong đó chỉ có hai trường đại học là Harvard và Cambridge, thành công trong việc tạo ra các bản mẫu thu nhỏ của bộ óc con người, với tên gọi “organoids”.
Những mẫu thí nghiệm này được phát triển dựa trên các tế bào gốc của bộ não con người, một trong số đó được xác định đã sản sinh ra sóng não tự phát, một thứ có thể bắt gặp trong quá trình hình thành nên một đứa bé, thậm chí còn có các dấu hiệu về quá trình hình thành nên thế giới quan nhận thức của các bộ não có kích thước thu nhỏ này.
Các nhà thần kinh học nhận định rằng, đây là một bước ngoặt trong y học, bởi nó có thể giúp chúng ta điều trị được các bệnh về não, nhưng một số khác lại cho rằng điều này đã vượt qua ranh giới về mặt đạo đức.
Theo đó, một số ý kiến cho rằng, những “organoids” rất có lợi cho những phát triển trong lĩnh vực y khoa, bởi nó có thể giúp các chuyên gia nghiên cứu được nhiều chi tiết mới về bộ óc con người. Một số khác lại lo ngại rằng những bộ óc này cũng sẽ có những nhận thức về mặt tình cảm, tức là nó có khả năng hình thành các trạng thái cảm xúc như buồn, vui, đau đớn…, thì đó là một vấn đề rất nghiêm trọng về mặt đạo đức.

Trong một buổi thuyết trình vào ngày 21 tháng 10, các nhà khoa học đến từ phòng thí nghiệm Green Neuroscience ở San Diego cho rằng, cần phải thiết lập giới hạn trong vấn đề này.
Elan Ohayon, giám đốc Phòng thí nghiệm khoa học thần kinh xanh tuyên bố: “Chúng tôi không muốn người ta làm thí nghiệm một thứ gì mà sẽ gây tác động, ảnh hưởng xấu đến nó cả. Chúng tôi đã chứng kiến cơ chế hoạt động của các ‘organoid’ này, chúng có những cơ chế phát triển sinh học giống ở động vật. Dù các mô não này có hình thái về cảm xúc hay không thì chúng ta đã cũng đã vượt quá ranh giới về đạo đức rồi.”
Các nhà khoa học tiếp tục đưa ra các bằng chứng nghiên cứu mang kèm: “Các đặc tính về thành phần cấu tạo ở các mẫu thể này giống với chất nền thần kinh về cấu trúc . Các tiến triển gần đây trong nghiên cứu về organoid cũng cho thấy rằng chất nền thần kinh sẽ tiếp cận được tới các thành phần bên trong, và lan tới các cấu trúc lớn hơn được tìm thấy ở những động vật có khả năng nhận thức. Do đó, những nghiên cứu về organoid đã chạm gần tới ranh giới về đạo đức.”
Ông Isaac Chen, một giáo sư trợ lý khoa phẫu thuật thần kinh của Trường Y khoa Penn’s Perelman và Trung tâm y tế Michael J. Crescenz VA, lại cho rằng: “Nhờ vào khả năng sao chép cơ chế hoạt động và phát triển của não bộ, những bộ óc ‘organoid’ với kích cỡ của bộ óc động vật này sẽ giúp chúng ta nghiên cứu được sâu hơn về các chứng rối loạn và các bệnh thần kinh. Tuy nhiên, lĩnh vực này đang phát triển một cách nhanh chóng, nên nếu tiếp tục nghiên cứu, các nhà nghiên cứu cần phải tuân theo các quy chuẩn chỉ dẫn về mặt đạo đức, dựa trên những nguyên tắc của khoa học trước khi thực hiện cấy ghép các organoid này lên động vật. Những quy chuẩn chỉ dẫn đó sẽ giúp họ tránh khỏi những rắc rối và tạo nên những lợi ích cho công cuộc nghiên cứu này mà không vướng phải các vấn đề về mặt đạo đức.”
Huy Hoàng (Theo Express)
Điều Cần Biết bank Squaland
Mua Bán Squaland
Nhà Tốt Squaland
News Squaland